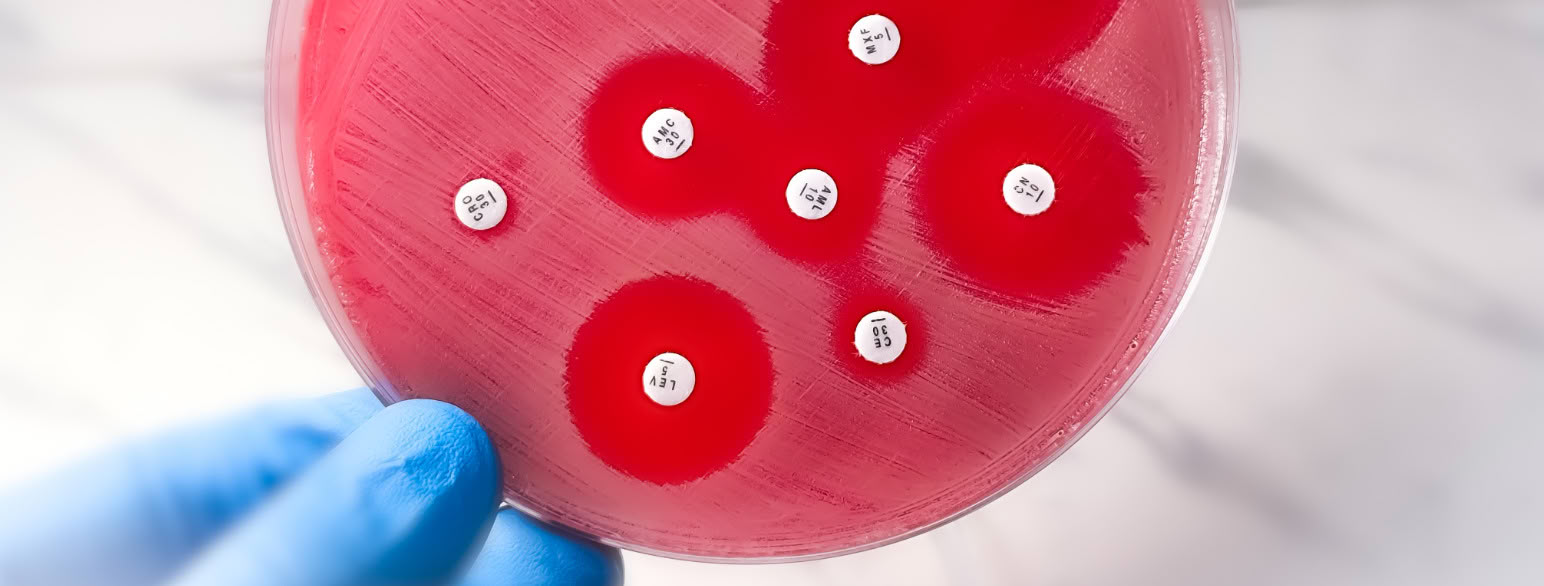

Antibiotika er legemidler som hemmer formeringen av eller dreper mikroorganismer. Midlene benyttes i behandling av infeksjonssykdommer over hele verden. Både mennesker, dyr og fisk kan behandles med antibiotika.
Penicillin er et eksempel på en type antibiotika. Den kan for eksempel brukes i behandling av lungebetennelse. I Norge må man ha resept fra en lege for å kunne kjøpe antibiotika. Det er bare apotekene som selger antibiotika. Dette er viktig for å forebygge antibiotikaresistens.
Mikroorganismer som kan forårsake infeksjon hos mennesket inndeles i bakterier, virus, sopp og parasitter. Antibiotika virker bare mot bakterier. Legemidler mot virus kalles antiviralia, mens legemidler mot sopp kalles antimykotika. Legemidler mot parasitter kalles antiparasittære legemidler. Det finnes flere titalls ulike legemidler innenfor hver gruppe.
Mange antibiotika lages naturlig av enkelte mikroorganismer i naturen. Noen antibiotika kan også fremstilles kjemisk i laboratorier.
Oppdagelsen av antibiotika er av flere sett på som en av de største framskrittene i medisinsk historie. Moderne medisin i dag med blant annet transplantasjoner, immunbehandling, cellegift og proteser er avhengig av antibiotika for å kunne gjennomføres.

Kommentarer
Kommentarer til artikkelen blir synlig for alle. Ikke skriv inn sensitive opplysninger, for eksempel helseopplysninger. Fagansvarlig eller redaktør svarer når de kan. Det kan ta tid før du får svar.
Du må være logget inn for å kommentere.